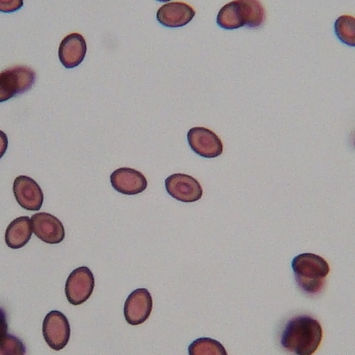

FREQUENTLY ASKED QUESTIONS
General Questions
Mold & Health Questions
Black Mold & Toxic Mold
Mold Questions
Mold Inspection Questions
ERMI Inspection Questions
Allergen Inspection Questions
Water Test Questions
Infrared Thermography Questions

MOLD GLOSSARY
Molds species are simple, microscopic organisms that can grow virtually anywhere, both inside buildings and outdoors. Mold colonies can grow inside damp or wet building structures and are a common component of household and workplace dust.
Health effects from exposure to mold can vary greatly depending on the person and the amount and type of mold present, some toxic and some allergenic.
Regardless of the type of mold, it should be treated as potentially a health hazard and should be removed from homes and workplaces.
As there are thousands of species this cannot be a conclusive list, however, we are listing the most common spores found indoors in the Central Florida area.


Alternaria is a plant pathogen, and some species are also parasitic on living plants. In fact, statistics show that at least 20% of lost agricultural yields are due to various Alternaria species, and sometimes, these losses can reach up to 80%.
Many species of Alternaria have been known to cause health problems in humans. They produce mycotoxins that affect the respiratory system, skin and nails. Other species are common allergens that may lead to asthma, hay fever, etc., but they rarely cause serious infections. They are of particular risk to immuno-suppressed and wounded individuals.
Potential Health Effects
Allergens
Commonly recognized.
Type I allergies (hay fever, asthma).
Type III hypersensitivity pneumonitis: Woodworker's lung, Apple store hypersensitivity.
May cross react with Ulocladium, Stemphylium, Phoma, others.
Potential Opportunist or Pathogen
Nasal lesions, subcutaneous lesions, nail infections; the majority of infections reported from persons with underlying disease or in those taking immunosuppressive drugs. Most species of Alternaria do not grow at 37°C.
Potential Toxin Production
A. alternata produces the antifungal alternariol. Other metabolites include AME (alternariol monomethylether), tenuazonic acid, and altertoxins (mutagenic).

Potential Health Effects
Allergens
One species, Arthrinium sphaerospermum, reported as an allergen.
Potential Opportunist or Pathogen
Not known.
Potential Toxin Production
Not known

Potential Health Effects
Allergens
Common.
Type I allergies (hay fever, asthma).
Type III hypersensitivity pneumonitis: Humidifier lung, Malt worker's lung, Compost lung, Wood trimmer's disease, Straw hypersensitivity, Farmer's lung, Oat grain hypersensitivity, others.
Other: A. fumigatus: allergic bronchopulmonary aspergillosis (ABPA), allergic fungal sinusitis.
Potential Opportunist or Pathogen
Respiratory, invasive, cutaneous, ear, and corneal disease. Severe, invasive disease is usually associated with immunosuppressed hosts. Many species grow at 37°C (body temperature).
A. fumigatus: fungus ball and invasive disease.
A. flavus: nasal sinus lesions, invasive disease.
A. niger: "Swimmer's ear," and invasive disease.
Potential Toxin Production
Partial list:
A. flavus: aflatoxin B1 & B2, cyclopiazonic acid, kojic acid
A. fumigatus: ergot alkaloids, fumigaclavines, gliotoxin, fumigatoxin, fumigillin, fumitremorgens, helvolic acid, tryptoquivaline tremorgens, verruculogen.
A. niger: malformin C, oxalic acid.
A. ustus: austocystins.
A. versicolor: aspercolorin, averufin, cyclopiazonic acid, sterigmatocystin, versicolorin.

Potential Health Effects
Allergens
Highly variable, dependent on genus and species. Poorly studied.
Potential Opportunist or Pathogen
Dependent on genus and species, but the vast majority do not cause disease.
Potential Toxin Production
Very many, dependent on genus and species.

Potential Health Effects
Allergens
Probably common.
Type I allergies (hay fever, asthma).
Type III hypersensitivity pneumonitis: Lycoperdonosis (puffball spores), Mushroom culture hypersensitivity.
Potential Opportunist or Pathogen
Asexual forms may cause rare opportunistic infections.
The yeast Cryptococcus neoformans is a basidiomycete.
Potential Toxin Production
Mushroom toxicosis (poisoning) is usually a result of ingestion of the following toxins: amanitins, monomethyl-hydrazine, muscarine, ibotenic acid, psilocybin

Potential Health Effects
Allergens
Common.
Type I allergies (hay fever, asthma).
Other: Most commonly reported cause of allergic fungal sinusitis.
Potential Opportunist or Pathogen
Occasionally a cause of phaeohyphomycosis, including keratitis, sinusitis, and osteomyelitis. These infections most often occur in immunocompromised persons, although infections also occur in normal hosts. One case of brain abscess reported in an immunocompromised patient.
Potential Toxin Production
Not known.

Potential Health Effects
Allergens
Type I allergies (hay fever, asthma).
Type III hypersensitivity pneumonitis: Winegrower's lung.
Potential Opportunist or Pathogen
Very rare agent of keratomycosis. No recorded human cases of infection.
Potential Toxin Production
None known.

Potential Health Effects
Allergens
Not well studied.
Type I allergies (hay fever, asthma).
Potential Opportunist or Pathogen
Uncommon agent of onychomycosis (nail infection).
Potential Toxin Production
Chaetomin. Chaetomium globosum produces chaetoglobosins. Sterigmatocystin is produced by rare species. Other compounds produced (which may not be mycotoxins in the strict sense) include a variety of mutagens.

Potential Health Effects
Allergens
Common and important allergen.
Type I allergies (hay fever, asthma).
Type III hypersensitivity pneumonitis: Hot tub lung, Moldy wall hypersensitivity.
Potential Opportunist or Pathogen
Generally, non-pathogenic. One species, Cladosporium carrionii, is an agent of chromoblastomycosis in subtropical and tropical regions (grows at 35-37°C).
Potential Toxin Production
Cladosporin, emodin.

Potential Health Effects
Allergens
Common.
Type I allergies (hay fever, asthma).
Other: A relatively common cause of allergic fungal sinusitis.
Potential Opportunist or Pathogen
Occasionally a cause of onychomycosis, ocular keratitis, sinusitis, mycetoma, pneumonia, endocarditis, cerebral abscess, and disseminated infection. Most cases are from immunocompromised patients.
Potential Toxin Production
Not known.

Potential Health Effects
Allergens
Common.
Type I allergies (hay fever, asthma).
Potential Opportunist or Pathogen
No cases of infection have been reported in humans or animals.
Potential Toxin Production
Antibiotic substances produced: flavipin, epicorazine A & B, indole-3-acetonitrile.

Potential Health Effects
Allergens
Type I allergies (hay fever, asthma).
Potential Opportunist or Pathogen
Causes keratitis, endophthalmitis, onychomycosis, mycetoma, and disseminated infection in immunocompromised patients; infections in burn victims, and systemic opportunistic infections in severely disabled hosts.
Potential Toxin Production
Trichothecenes (type B); T-2 toxin; zearalenone (F-2 toxin), vomitoxin, deoxynivalenol, and fumonisin. Zearalenone is not acutely toxic, and actually may have positive effects with controlled ingestion.
Potential Health Effects
Allergens
Probably common.
Type I allergies (hay fever, asthma).
Type III hypersensitivity pneumonitis: Lycoperdonosis (puffball spores), Mushroom culture hypersensitivity.
Potential Opportunist or Pathogen
Asexual forms may cause rare opportunistic infections.
The yeast Cryptococcus neoformans is a basidiomycete.
Potential Toxin Production
Mushroom toxicosis (poisoning) is usually a result of ingestion of the following toxins: amanitins, monomethyl-hydrazine, muscarine, ibotenic acid, psilocybin

Potential Health Effects
Allergens
Not studied.
Potential Opportunist or Pathogen
Not known.
Potential Toxin Production
Trichothecenes (trichodermol and trichodermin) and griseofulvins. Trichothecene toxicity is due to the ability to bind ribosomal protein. Griseofulvin has been made commercially available as an anti-dermatophyte drug.

Monodictys is a genus of mold that is assigned to the form classification (i.e. based on morphology) of “hyphomycetes”. Hyphomycetes molds lack a closed fruiting body and are anamorphic (having an asexual reproductive stage).
Monodictys sp. are dematiaceous, a term that refers to its colonies’ dark appearance that results from the melanization of its cell walls. Colonies appear dark gray, brown, or black. Even the mycelium of this mold has a dark yellow or brown color. [1]
As of this writing, this genus of mold is not known to be listed in clinical medical references.
In nature, Monodictys sp. are found on twigs, apple trees, oak, seeds, other plants and plant matter (either alive or dead), dung, bones, and soil composites. They are often found growing with the aleuriosporous (i.e. its spores are releasing) form of the fungus Neta quadriguttata.
Also of interest is one species that is lichenicolous (Monodictys anaptychia) [2], meaning it is a parasitic fungus that only lives on lichen as the host.
In the indoor environment, Monodictys sp. have been identified on paper, cloth, and water-damaged wood, so home and building furnishings and some structural components can be at risk when wet or when the indoor humidity is too high.

Potential Health Effects
Allergens
Type I allergies (hay fever, asthma).
(Lycogala used in one skin test survey.)
Potential Opportunist or Pathogen
No reports of human infection.
Potential Toxin Production
None.

Potential Health Effects
Allergens
Type I allergies (hay fever, asthma).
Potential Opportunist or Pathogen
Very rare report of human infection.
Potential Toxin Production
Not known.

Potential Health Effects
Allergens
Type I allergies (hay fever, asthma).
Type III hypersensitivity pneumonitis: Humidifier lung.
Potential Opportunist or Pathogen
Although Paecilomyces grows at 37°C, human disease is relatively rare. Mycotic keratitis in conjunction with corneal implants, nosocomial infections, endocarditis, infections in immunocompromised patients are reported.
Potential Toxin Production
Paecilotoxins, byssochlamic acid, variotin, ferrirubin, viriditoxin, indole-3-acetic acid, fusigen and patulin.

Potential Health Effects
Allergens
Not studied.
Potential Opportunist or Pathogen
No reports of infections.
Potential Toxin Production
Sporidesmin.

Scopulariopsis is a large genus comprising mainly soil species. Species are frequently isolated from food and building materials such as drywall paper and wood. This fungus has relatively high water activity similar to Stachybotrys. Very little is known about the health effects of this fungus. Certain species may be involved in human onychomycoses or pulmonary mycoses. Scopulariopsis has been recovered from culturable air, spore trap, and dust samples. Its Teleomorph, Microascus, has also been recovered from indoor building material.

This organism is rarely found in outdoor samples. Grows well on wet media, preferably containing cellulose. It proliferates in the indoor environment with long term water damage, growing on wallpaper, gypsum board, and textiles. As a general rule, air cultures for Stachybotrys yields unpredictable results, mainly due to the fact that this fungus is usually accompanied by other fungi such as Aspergillus and Penicillium that normally are better aerosolized than Stachybotrys. This is a slow growing fungus on media. It does not compete well with other rapidly growing fungi. The black fungi grow on building material with high cellulose content and low nitrogen content. Appropriate media for the growth of this organism will have high cellulose content and low nitrogen content.
Potential Health Effects
Allergens
Not well studied.
Type I allergies reported.
Potential Opportunist or Pathogen
No reports of human infection. (No species grow well at 37°C.)
Potential Toxin Production
Macrocyclic trichothecenes: verrucarin J, roridin E, satratoxin F, G & H, sporidesmin G, trichoverrol; cyclosporins, stachybotryolactone.
Stachybotrys mycotoxicosis: human toxicosis has been described; may be characterized by dermatitis, cough, rhinitis, itching or burning sensation in mouth, throat, nasal passages and eyes. The best described toxicoses are from domestic animals that have eaten contaminated hay and straw or inhaled infected material from contaminated bedding.

Potential Health Effects
Allergens
Type I allergies (hay fever, asthma).
Potential Opportunist or Pathogen
No reports of human infection.
Potential Toxin Production
Torula herbarum was cytotoxic in screening tests performed by our laboratory. The nature of the toxin(s) is unknown.

Potential Health Effects
Allergens
Major.
Type I allergies (hay fever, asthma).
Ulocladium cross-reacts with Alternaria, adding to the allergenic burden of Alternaria-sensitive patients.
Potential Opportunist or Pathogen
Rare subcutaneous tissue infection.
Potential Toxin Production
Not known.

Zygomycetes are one of the four major groups of fungi, the others being the Oomycetes, the Ascomycetes, and the Basidiomycetes. Zygomycetes are common, fast growing, and often overgrow and/or inhibit other fungi nearby. Rhizopus and Mucor are two of the most common Zygomycetes seen in the indoor environment. However, others are seen as well, including Syncephalastrum, Circinella, Mortierella, Mycotypha, Cunninghamella, and Choanephora. For further information, please see descriptions of these individual genera.
